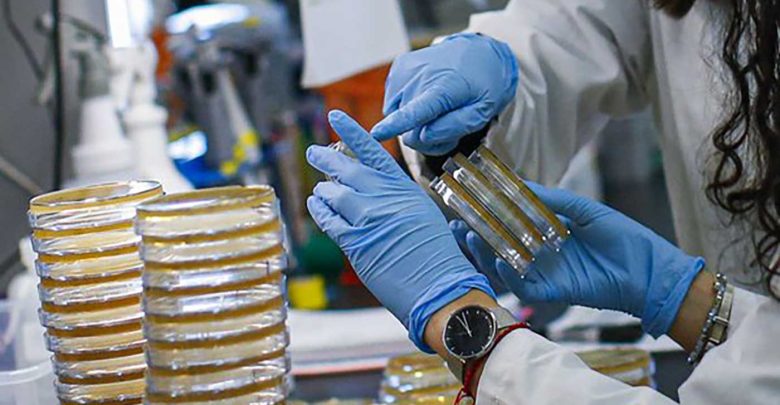

20 مليون إصابة كورونا.. وأميركا والبرازيل والهند في الصدارة
تجاوز عدد الإصابات بفيروس كورونا في العالم، الاثنين، 20 مليون شخص، في حين تخطى عدد الوفيات 734 ألفا، ولا تزال الولايات المتحدة والبرازيل والهند تتصدر دول العالم من حيث عدد الإصابات.
وذكر موقع “وورد ميترز”، المختص في رصد الإصابات والوفيات الناجمة عن فيروس كورونا في العالم، أن عدد الإصابات وصل إلى 20 مليونا ونحو 32 ألفا، حتى لحظة إعداد هذا التقرير.
وأشار الموقع نفسه إلى أن عدد الوفيات بمرض “كوفيد 19″، الناجم عن الإصابة بفيروس كورونا، بلغ 734 ألفا و98 وفاة بالعالم، مبينا أن عدد المتعافين وصل إلى 12 مليونا وأكثر من 904 آلاف شخص.
ولا تزال الولايات المتحدة تتصدر العالم بعدد الإصابات بخمسة ملايين ونحو 200 ألف حالة، تليها البرازيل بثلاثة ملايين وأكثر من 35 ألفا إصابة، وتأتي الهند في المرتبة الثالثة بملونين وأكثر من 215 ألف حالة.
وسجلت السلطات الروسية، الاثنين، 5118 إصابة جديدة بفيروس كورونا، ليرتفع العدد الإجمالي للحالات في البلاد إلى 892 ألفا، و654 إصابة، وهو ما يمثل رابع أعلى عدد إصابات في العالم.
أما عن الوفيات، فقد سجلت الولايات المتحدة أكثر من 165 ألف وفاة، تليها البرازيل بما يزد عن 100 ألف، ثم المكسيك ثالثة بأكثر من 52 ألف وفاة.
وجاءت بريطانيا في المرتبة الرابعة من حيث عدد الوفيات بفيروس كورونا بأكثر من 46 ألف وفاة، في حين سجلت الهند أكثر من 44 ألف حالة وفاة لتكون في المركز الخامس.



